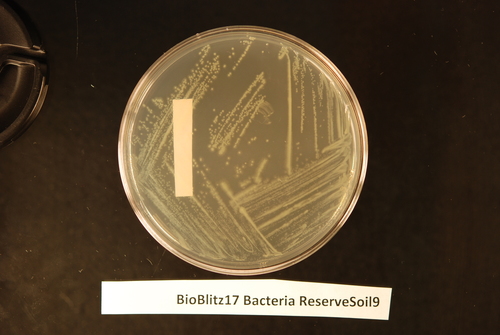
Family Comamonadaceae · iNaturalist

Comamonadaceae es una familia de bacterias del orden Burkholderiales. Fue descrita en el año 1991.[1] Engloba a bacterias gramnegativas, en general aerobias y móviles mediante flagelo polar, aunque existen excepciones, pudiendo encontrar especies anaerobias facultativas y otras inmóviles o con flagelación perítrica.[2] Tienen forma de bacilo, y algunas especies pueden ser algo curvadas. Suelen ser mesófilas, con temperaturas de crecimiento entre 24-35 °C, y forman colonias que van desde el incoloro al amarillo.
Se encuentran en una amplia variedad de ambientes, mayoritariamente en aguas, suelos y lodos. Aunque en general no se consideran bacterias patógenas, algunas especies pueden causar enfermedades en plantas, cómo miembros de los géneros Acidovorax y Xylophilus, o en humanos, cómo algunas especies de Comamonas, Acidovorax, Delftia y Xenophilus, aunque su aislamiento es raro o anecdótico.
Taxonomía
Actualmente hay descritos 53 géneros de esta familia, que abarcan más de 200 especies:[3]
Referencias